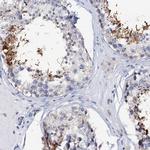
AKAP3 Antibody in Immunohistochemistry (IHC)

Search
Invitrogen
AKAP3 Polyclonal Antibody
{{$productOrderCtrl.translations['antibody.pdp.commerceCard.promotion.promotions']}}
{{$productOrderCtrl.translations['antibody.pdp.commerceCard.promotion.viewpromo']}}
{{$productOrderCtrl.translations['antibody.pdp.commerceCard.promotion.promocode']}}: {{promo.promoCode}} {{promo.promoTitle}} {{promo.promoDescription}}. {{$productOrderCtrl.translations['antibody.pdp.commerceCard.promotion.learnmore']}}
产品信息
PA5-58920
种属反应
宿主/亚型
分类
类型
抗原
偶联物
形式
浓度
规格
纯化类型
保存液
内含物
保存条件
运输条件
RRID
产品详细信息
Immunogen sequence: AQGGRRDARS FVEAAGTTNF PANEPPVAPD ESCLKSAPIV GDQEQAEKKD LRSVFFNFIR NLLSETIFKR DQSPEPKVPE QPVKEDRKLC ERP
Highest antigen sequence identity to the following orthologs: Mouse - 60%, Rat - 61%.
靶标信息
The type II cAMP-dependent protein kinase (PKA) is a multifunctional kinase with a broad range of substrates. Specificity of PKA signaling is mediated by the compartmentalization of the kinase to specific sites within the cell. To maintain this specific localization, the R subunit (RII) of PKA interacts with specific RII-anchoring proteins, designated A-kinase anchoring proteins (AKAP). AKAP 3, also known as AKAP 110, FSP95, PRKA3 and SOB1, binds both PKA and PDE4A and functions as a scaffolding protein in spermatozoa to regulate local cAMP concentrations and modulate sperm functions. Expression of AKAP 3 in normal tissues is restricted to the testis, where bicarbonate stimulates tyrosine phosphorylation of AKAP 3, thereby increasing its recruitment of PKA. AKAP-3 also exhibits high expression in patients with epithelial ovarian cancer (EOC). It demonstrates tumor-restricted expression and appears to be associated with worse overall survival, which make AKAP 3 a potential target for antigen-specific immunotherapy in EOC.
仅用于科研。不用于诊断过程。未经明确授权不得转售。
篇参考文献 (0)
生物信息学
蛋白别名: A kinase (PRKA) anchor protein 3; A-kinase anchor protein 110 kDa; A-kinase anchor protein 3; A-kinase anchor protein, 110kDa; AKAP 110; AKAP-3; Cancer/testis antigen 82; CT82; epididymis luminal protein 159; epididymis secretory sperm binding protein; Fibrous Sheath Protein of 95 kDa; fibrousheathin 1; Fibrousheathin I; Fibrousheathin-1; FSP95; PKA binding protein; PRKA3; protein kinase A binding protein AKAP 110; Protein kinase A-anchoring protein 3; putative fibrous sheath protein; Sperm oocyte-binding protein; sperm oocyte-binding protein 1; unnamed protein product
基因别名: AKAP 110; AKAP110; AKAP3; CT82; FSP95; HEL159; PRKA3; SOB1; SPGF82
UniProt ID: (Human) O75969
Entrez Gene ID: (Human) 10566